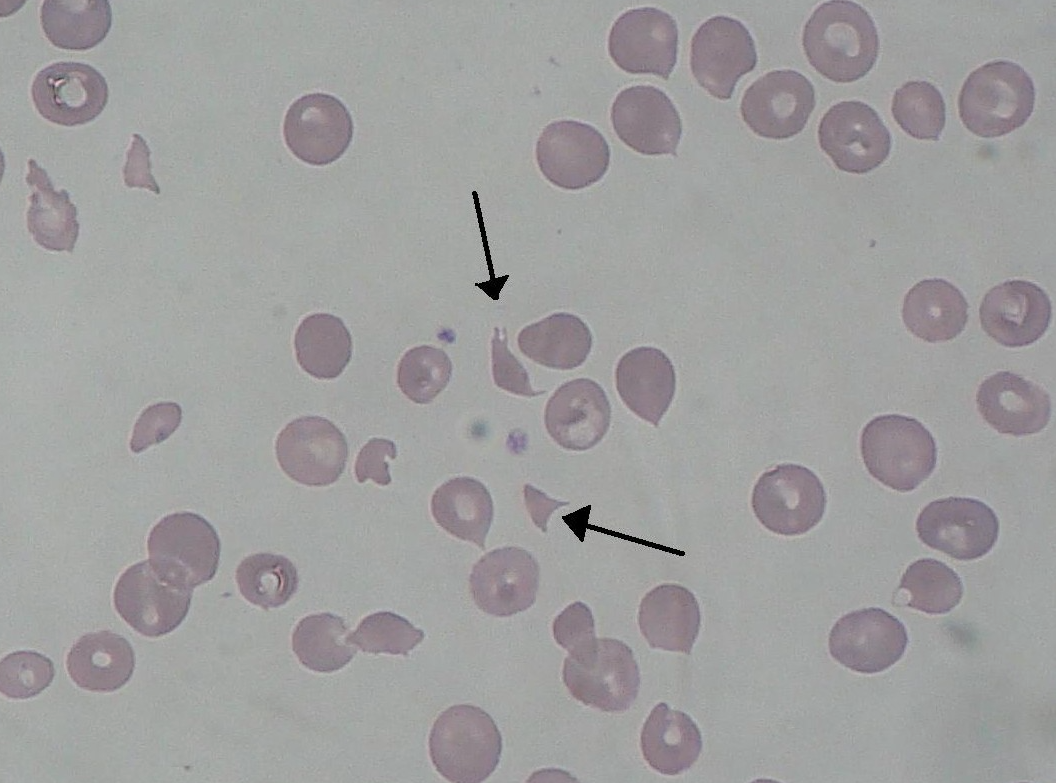

용혈성 요독 증후군(HUS)은
① 미세혈관병성 용혈성 빈혈(MAHA)
② 급성 신부전(ARF)
③ 혈소판 감소증(thrombocytopenia)
이 세 가지가 동시에 나타나는 전형적 triad 질환입니다.
소아에서 흔히 발생하며, 설사(혈변) 이후 발생하는 신부전을 볼 때 반드시 의심해야 합니다.
같은 증상이 있을때 소아에서는 HUS( 용혈성 요독 증후군 )를
성인에서는 TTP ( 혈전성 혈소판감소성 자반증)를 생각해야합니다.

용혈성 요독 증후군(HUS)는 크게 설사 연관형(typical)과 비설사형(atypical)으로 나눕니다.
설사 연관형 (Typical HUS) 은 소아에서 흔한 전형적인 형태입니다.
원인은 STEC (Shiga toxin-producing E. coli, O157:H7), Shigella dysenteriae type 1 라고하는
대장균에의한 Shiga toxin 혹은 쉬겔라균에의한 독소에 의한 것으로
Shiga toxin이 혈관 내피 손상을 유발하는 것이 기전입니다.

비설사형 (Atypical HUS)은 설사 없이 발생하는 형태로
선천적/후천적 ADAMTS13 결핍 으로 인해 vWF multimer 분해 억제에의한것이나
감염(폐렴, 장티푸스, 신생아 패혈증)에 의한것
보체 조절인자(Factor H) 결핍 등에 의한 것 등 드물게 발생합니다.
전형적인 HUS 의증상 3가지는
용혈성 빈혈 (MAHA)
신장 손상
혈소판 감소
3가지입니다.

전구 증상으로 나타나는 것은
설사(혈변), 발열, 복통, 탈수 등입니다.
이후 5~10일 내 혈액학적 증상 3가지가 진행됩니다.

용혈성 빈혈로 인한 빈혈 증상으로인해 창백, 부종, 기면이발생하며
신부전이발생하여 혈뇨, 단백뇨, 고혈압, 부종, BUN/Cr 상승 (2~6주 지속) 이 이어지며,
출혈성경향으로 인해 피부, 위장관 출혈이 발생합니다.

간 침범이 있는 경우 황달, 간비대가 나타나며
CNS 병변이 동반되는 경우 경련, 마비, 혼수 상태에 빠지는것도 가능합니다.
진단의 핵심은 Triad = MAHA + ARF + Thrombocytopenia 3가지 증상 여부를 보는것입니다.
용혈성 빈혈 (MAHA)는 말초혈액도말(PBS)에서 schistocyte(분절 적혈구)를 확인하고
신장 손상은 혈뇨, 단백뇨, BUN/Cr 상승을 확인하며
혈소판 감소는 말초혈액에서 혈소판 수치 감소를 확인합니다.
추정 진단으로 설령 설사 병력이 없더라도 triad가 있으면 HUS 의심해야하며
확진은 최근 3주 내 설사 병력 + 3가지 소견(빈혈/혈소판감소/신부전) + 조직학적 미세혈관병 확인에 의거합니다.
설사 후 급성 신부전 이 있는 경우, 반드시 HUS를 의심해야합니다.
'소아 신장요로질환' 카테고리의 다른 글
| 소아 요로감염 (Urinary tract infections, UTI) (0) | 2025.09.15 |
|---|---|
| 용혈성 요독 증후군 (Hemolytic uremic syndrome, HUS) – 검사 소견, 진단, 치료, 예후 (0) | 2025.09.15 |
| 양성 가족성 혈뇨 (Thin Glomerular Basement Membrane Thin GBM Disease , TBMD nephropathy) (0) | 2025.09.14 |
| 알포트 증후군 (Alport syndrome) 증상 치료 원인 유전자 (0) | 2025.09.14 |
댓글